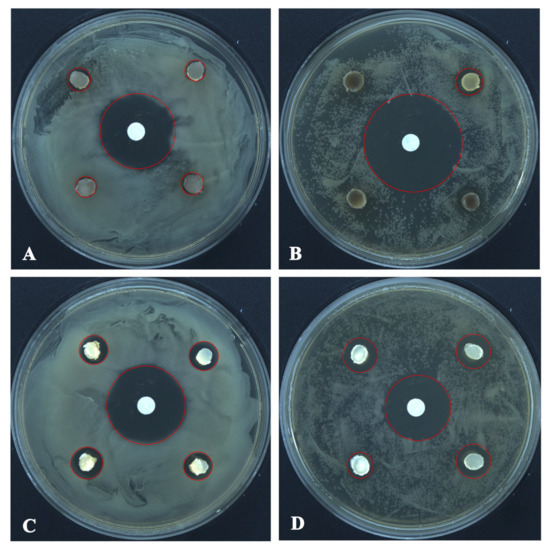

Abstract
During a survey of ascomycetous fungi associated with plant litter and submerged wood in Jilin Province, China, two hyphomycetous fungi were discovered. Morphological examination and molecular phylogenetic analyses revealed that these isolates represent two species within the genus Torula, which are herein described as Torula changchunensis sp. nov. and a new host record of T. mackenziei. Detailed morphological characteristics are provided, and the phylogenetic relationships of the new species are also discussed. The new species differs from T. chinensis and T. phytolaccae by having smaller conidiogenous cells, smaller conidia, and fewer septa. Preliminary assessments were conducted on T. changchunensis and T. mackenziei to evaluate their antagonistic activity against two pathogenic fungi (Cladobotryum mycophilum and Botrytis cinerea) and two pathogenic bacteria (Staphylococcus aureus and Bacillus subtilis). Torula changchunensis sp. nov. exhibited 67.18% inhibition against C. mycophilum and moderate inhibition against the pathogenic bacteria, whereas Torula mackenziei showed moderate-to-weak inhibitory activity against both pathogenic fungi and bacteria.
1. Introduction
The family Torulaceae, established by Corda and typified by Torula Pers. [1], represents a distinct lineage within the order Pleosporales. Currently, this family is known only from its asexual morphs, which are characterized by grayish-brown to black, superficial, effuse, and powdery colonies; micro- or macronematous conidiophores, with or without apical branches; doliiform to ellipsoid or clavate, brown, smooth to verruculose, mono- to polyblastic conidiogenous cells; and brown, monilioid, phragmosporous, acrogenous, smooth to verrucose conidia [2,3,4,5,6,7,8]. Members of Torulaceae are commonly associated with persistent woody stems as saprobes and are occasionally pathogenic on dicotyledons [6,7,8,9,10,11,12,13]. Crous et al. [6] investigated the classification of this family and recognized Dendryphion and Torula as belonging to Torulaceae. Subsequently, the genera Cylindrotorula, Neotorula, Rostriconidium, Rutola, and Sporidesmioides were also accommodated within the family based on morphological characteristics and phylogenetic analyses [5,7,14,15,16].
Torula was established by Persoon in 1795, with T. herbarum (=T. monilis) designated as the type species [17]. Species of Torula are defined by distinct asexual morphological features, such as monoblastic or polyblastic, as well as terminal or lateral conidiogenous cells with a thickened, heavily melanized basal wall and a thin-walled apex that frequently collapses and becomes coronate [3]. Crane and Schoknecht (1977) documented the conidiogenesis of Torula species using light and transmission electron microscopy [18]. Similar observations were reported by Mason, Hughes, Subramanian, and other researchers, who contributed significantly to the understanding of phenotypic variation among Torula species [19,20,21,22,23]. To date, more than 500 epithets are listed under Torula in Index Fungorum (http://www.indexfungorum.org/; accessed on 16 April 2025), with many species transferred to other genera. Unfortunately, there is a shortage of molecular information for most Torula species [6], and for many of them, recollection and culture isolation will be necessary.
Members of Torula typically inhabit terrestrial and aquatic environments in temperate to tropical regions as saprobes [24]. Several species also occur as plant pathogens or endophytes. For example, T. herbarum has been reported as the causal agent of stem blight on Ziziphus mauritiana (Rhamnaceae) [12] and was also isolated from the surface of apple fruit, where it forms part of a fungal complex responsible for apple sooty blotch [13]. Additionally, T. herbarum has been identified as an endophyte on the leaves of Solanum nigrum [25]. Some Torula species were also detected in the air of natural environments around crop fields after harvest [26]. Moreover, this genus has been documented to produce various interesting secondary metabolites, such as a novel dechlorinated aromatic lactone, herbarin, dehydroherbarin, and o-methylherbarin, and has exhibited antibacterial, antifungal, antiamoebic, and potentially anticancer activities [27,28,29,30,31,32].
During a survey of saprobic fungi in Jilin Province, China, two isolates were obtained from woody substrates. In this study, we introduce a new species (Torula changchunensis) and a new record of T. mackenziei, which were collected from submerged wood and Xanthoceras sorbifolium (Sapindaceae), respectively. The new taxon was compared morphologically with other Torula species. Multi-gene phylogenetic analyses based on ITS, LSU, SSU, tef1-α, and rpb2 loci were performed to determine the taxonomic placement of the novel species. In addition, we tested the antimicrobial activities of these fungi in vitro to screen for new biocontrol agents.
2. Materials and Methods
2.1. Sample Collection, Isolation, and Morphological Observation
Decaying branches of X. sorbifolium were collected from Jilin Agricultural University, and submerged wood was collected from Jingyuetan National Scenic Area in Changchun, Jilin Province. The specimens were transferred to the laboratory in sealed plastic bags with labels describing specific collection information. A Zeiss Stemi 2000C stereomicroscope (ZEISS, Oberkochen, Germany) fitted with a Leica DFC450C digital camera (Leica, Wetzlar, Germany) was used to examine the macromorphological sample characteristics of samples from the host. Colonies on the substrate surface were transferred to a temporary slide with sterile water. Morphological characteristics and microscopic measurements were performed using a Zeiss AX10 light microscope equipped with an Axiocam 506 digital camera (ZEISS, Oberkochen, Germany). The photos were processed using Adobe Photoshop CC2019 (Adobe Systems, San Jose, CA, USA). The fungi were obtained by single-spore isolation methods described by Senanayake et al. [33]. Germinated conidia were transferred aseptically to the new potato dextrose agar (PDA) and incubated at 25 °C in dark.
Specimens were deposited in the Herbarium of Mycology, Jilin Agricultural University (HMJAU), Changchun, China. Pure fungal cultures were deposited in the International Cooperation Research Center of China for New Germplasm Breeding of Edible Mushrooms Culture Collection (CCMJ) and the Engineering Research Center of Edible and Medicinal Fungi, Ministry of Education culture collection (EMFCC), Changchun, China. The new taxon was registered in Mycobank [34].
2.2. DNA Extraction, PCR Amplification, and Sequencing
After culturing the isolates in PDA at 25 °C for 2 weeks, the mycelium from the pure cultures was collected and flash-frozen with liquid nitrogen. Genomic DNA was extracted using a NuClean PlantGen DNA Kit (CWBIO, Taizhou, China), adhering to the instructions provided by the manufacturer. The internal transcribed spacer regions (ITS), large subunit (LSU) rDNA, small subunit (SSU) rDNA, translation elongation factor 1-alpha gene (tef1-α), and the RNA polymerase II second-largest subunit (rpb2) were amplified by polymerase chain reaction (PCR) using ITS5/ITS4 [35], LR0R/LR5 [36], NS1/NS4 [35], TEF1-983F/TEF1-2218R [37,38], and fRPB2-5F/fRPB2-7cR [39] primer pairs, respectively. The amplification reactions were performed using 20 μL PCR mixtures containing 9 μL of sterilized water, 10 μL of 2 × Es Taq MasterMix (Dye) (CWBIO, Taizhou, China), 0.3 μL of forward and reverse primers, and 0.4 μL of the DNA template. The amplification conditions were as follows: 94 °C for 5 min, then 35 cycles of denaturation at 94 °C for 30 s, annealing at 55 °C for 45 s, elongation at 72 °C for 90 s, and a final extension at 72 °C for 10 min. The PCR products were confirmed on 1% agarose electrophoresis gels stained with standard DNA dye. Purification and sequencing were conducted at Sangon Biotech Co. in Shanghai, China.
2.3. Phylogenetic Analysis
The preliminary identification of the new strains was carried out by using BLASTn searches (https://www.ncbi.nlm.nih.gov/, accessed on 18 June 2024), and the newly generated nucleotide sequence data were deposited in GenBank. Our newly obtained sequences, along with those from recent publications [11,16,40] and the GenBank database, used in the phylogenetic analysis, are displayed in Table 1. Roussoella hysterioides (CBS 125434 and CBS 546.94) was selected as the outgroup. The individual gene sequences were assembled using BioEdit version 7.2.5 [41], aligned with MAFFT version 7 (http://mafft.cbrc.jp/alignment/server/index.html, accessed on 6 February 2025), and adjusted manually in AliView [42,43]. The sequence datasets were combined using SequenceMatrix v.1.7.8 [44].

Table 1.
Taxa dataset used in the phylogenetic analyses with information on strain/isolate, host, and country. The ex-types are in bold, and the newly generated sequences are in blue.
The phylogenetic trees were prepared using both maximum likelihood (ML) and Bayesian inference (BI) analyses. ML analysis was conducted using RAxML-HPC2 on XSEDE (version 8.2.12), accessible via the CIPRES web portal (http://www.phylo.org/portal2/, accessed on 10 February 2025) [45], with an RAxML rapid bootstrapping of 1000 replicates. The best-fit evolutionary models for both individual and combined datasets were calculated using the Akaike Information Criterion (AIC) with jModeltest 2.1.10 on the CIPRES web portal [46]. BI analyses were performed using MrBayes version 3.2.6 on the CIPRES web portal [47], with simultaneous Markov chains running for 5,000,000 generations and trees sampled every 100th generation. Finally, phylogenetic trees were illustrated in FigTree 1.4.3 [48] and edited using Microsoft Office PowerPoint. The ML bootstrap support values (ML, greater than or equal to 70%) and Bayesian posterior probability values (BPP, greater than or equal to 0.90) are shown on the branches at the nodes.
2.4. Preliminary Assessment of Antagonistic Effects on Pathogens
To determine the antimicrobial activity of T. mackenziei (CCMJ 13080) and T. changchunensis (EMFCC 0042), the pathogen isolates of Cladobotryum mycophilum (C. mycophilum), Botrytis cinerea (B. cinerea), Staphylococcus aureus (S. aureus), and Bacillus subtilis (B. subtilis) were obtained from CCMJ and used as indicator strains. The working cultures of these pathogens were prepared by transferring mycelium/bacteria colonies onto PDA and lysogeny broth (LB) plates and incubating them for 6 days at 25 °C and for 2 days at 30 °C, respectively.
Dual culture testing in vitro was carried out to screen the antagonism of T. mackenziei (CCMJ 13080) and T. changchunensis (EMFCC 0042) against the fungal pathogens [49]. A 6 mm fungal pathogen disk was placed on one side of a 9 cm diameter PDA plate. Meanwhile, a 6 mm antagonistic fungal disk was positioned in a symmetrical location on the opposite side of the pathogen disk, maintaining a distance of 3 cm from the pathogen and 2 cm from the edge of the PDA plate. Plates inoculated only with the cultures of fungal pathogens served as negative controls. The plates were incubated at 25 °C for one week. The assay was replicated three times. The radial growth of fungal colonies was documented, and the percentage of mycelial growth inhibition (PGI) was determined using the following formula: PGI (%) = (R1 − R2)/R1 × 100 [50], where R1 is the radial growth of the control pathogen and R2 is the radial growth of the pathogen in confrontation with each isolate. Statistical analysis of variance (ANOVA) and the least significant difference (LSD) test, where p ≤ 0.05, were performed using SPSS Statistics version 22 (SPSS, Inc., Chicago, IL, USA).
For evaluating the antagonism between pathogenic bacteria and indicator strains, we put 200 µL of bacterial suspensions with adjusted concentrations into the PDA medium, and then transferred stock agar plugs containing antagonistic fungus mycelium onto culture dishes containing pathogenic bacteria, inoculating each dish with four agar plugs. The control was placed on a filter paper in the center, and streptomycin sulfate (30 μg/mL) was dropped onto each filter paper. The assay was replicated three times, and observations of the inhibition zone were carried out after 24 h at 37 °C.
3. Results
3.1. Phylogenetic Analyses
The combined dataset of ITS, LSU, SSU, tef1-α, and rpb2 genes comprised 41 strains, including our newly sequenced strains. Multi-locus sequences were concatenated, which comprised 4069 characters, including gaps (ITS: 1–514; LSU: 515–1346; SSU: 1347–2304; tef1-α: 2305–3128; rpb2: 3129–4069). The GTR + I + G was the best model used for the analysis of all datasets. The best-scoring RAxML tree had a final optimization likelihood value of −15947.007918. The matrix had 1036 distinct alignment patterns, with 23.14% of undetermined characters or gaps. Estimated base frequencies were as follows: A = 0.247649; C = 0.261367; G = 0.268353; and T = 0.222631. Substitution rates were AC = 2.079376; AG = 4.432116; AT = 1.800766; CG = 1.236905; CT = 10.709148; and GT = 1.000000. The proportion of invariable sites was I = 0.588501; the gamma distribution shape parameter was α = 0.440095. In the BI analysis, a total of 98 trees were sampled after the 20% burn-in phase, with a stop value of 0.008597. The topologies of ML and BI analysis were congruent (Figure 1 and Figure S1).

Figure 1.
Phylogenetic tree of Torula generated from Bayesian inference analysis based on combined ITS, LSU, SSU, tef1-α, and rpb2 sequence data. Maximum likelihood bootstrap support values ≥ 70% (ML) and Bayesian posterior probabilities ≥ 0.90 (BPP) are given at the nodes as ML/BPP. The tree is rooted with Roussoella hysterioides (CBS 125434, CBS 546.94). The type strains are in bold, and the new strains are in red.
The phylogenetic results shown in Figure 1 demonstrated an undescribed species and one known species. Our strains of CCMJ 13080 and CCMJ 13081 grouped together with the ex-type strain of T. mackenziei (MFLUCC 13-0839) with a bootstrap support of 90% ML and 0.91 BPP. The newly described taxa T. changchunensis (EMFCC 0042, EMFCC 0046) formed an independent lineage and clustered with T. phytolaccae (ZHKUCC 22-0107, ZHKUCC 22-0108) and T. chinensis (UESTCC 22.0085) with 57% ML and 1.00 BPP support.
3.2. Taxonomy
Torula mackenziei J.F. Li, Phookamsak & K.D. Hyde, Mycol. Progress 16 (4): 455 (2017), new host record and new geological record (Figure 2).

Figure 2.
Torula mackenziei (HMJAU 64848). (a) Colonies on host substrate. (b,c) Conidia in catenated chain. (d) Conidiophores with conidiogenous cells. (e–l) Conidia. (m) Culture characteristics on PDA. Scale bars: (a) = 100 μm; (b−e,g−h) = 20 μm; (f,i−l) = 10 μm.
Index Fungorum number: IF819537; Facesofungi number: FoF 02714.
Description. Saprobic on decaying branches of Xanthoceras sorbifolium. Sexual morph: Undetermined. Asexual morph: Hyphomycetous. Colonies effuse, black, powdery on natural substrate. Mycelium immersed, composed of branched, smooth-walled, septate, light brown hyphae. Conidiophores 7–22 (−38) × 3–5 μm ( = 13 × 4 μm, n = 10), solitary, micronematous to semi-macronematous, mononematous, erect, minutely verruculose, without apical branches, thick-walled, sometimes reduced to conidiogenous cells, ellipsoid to subglobose, brown. Conidiogenous cells 4–9 × 3–6 μm ( = 7 × 4 μm, n = 10), globose to ellipsoid, integrated, blastic, terminal, paler at apex, smooth to minutely verruculose, brown, thick-walled. Conidia (5−) 11–23 × 4–9 μm ( = 14 × 6 μm, n = 50), yellowish brown to dark brown, acrogenous, phragmosporous, catenated, rounded at both ends, paler at apex, smooth to minutely verruculose, composed of globose to doliiform cells, 1–3-septate, constricted at septa, monilioid, with conidial chains in branches. Conidial secession schizolytic.
Culture characteristics. Colonies on PDA reaching 30 mm in diameter after 10 days at 25 °C. Cultures from above, dense, circular, cottony, covered with white, fluffy-like aerial mycelium, entire edges, paler yellowish, radiating outwardly. The reverse side is a pale pink in the center that gradually extends outwards, while the color changes to dark brown with creamy yellow.
Material examined. CHINA, Jilin Province, Changchun city, Jilin Agriculture University, on decaying branches of Xanthoceras sorbifolium (Sapindaceae), 17 June 2021, XR22.1 (HMJAU 64848), living culture CCMJ 13080; Siping city, forest farm in Lishu County, on decaying branches of Xanthoceras sorbifolium (Sapindaceae), 20 August 2021, Rong Xu, XR22.2 (HMJAU 64849), living culture CCMJ 13081.
Distribution. China, Thailand.
Notes. Li et al. [8] first reported Torula mackenziei, which was isolated from a dead branch of Bidens pilosa (Asteraceae) in Thailand. Subsequently, this species was also collected from submerged wood in southwest China, with the morphology characterized by larger conidiophores, conidiogenous cells, and conidia [16]. Our new isolates (HMJAU 64848 and HMJAU 64849) have similar morphologies to the holotype specimen of T. mackenziei (MFLU 16-2820). Pairwise sequence comparisons between the new isolates and the holotype revealed minor differences. In the multi-gene phylogenetic analyses, our strains (CCMJ 13080 and CCMJ 13081) derived from this study clustered with the other T. mackenziei strain (MFLUCC 13-0839) with high statistical support (90% ML, 0.91 BYPP). This is a new record of T. mackenziei collected from Sapindaceae in northeastern China.
Torula changchunensis R. Xu & Y. Li, sp. nov. (Figure 3)

Figure 3.
Torula changchunensis (HMJAU 64900, holotype). (a–c) Colonies on host substrate. (d–g) Conidiophores with conidiogenous cells. (h–m) Conidia. (n–p) Conidia in catenated chain. (q) Culture characteristics on PDA. Scale bars: (a−c) = 500 μm; (d−g) = 5 μm; (h−p) = 10 μm.
MycoBank number: 856481
Etymology: Referring to Changchun city, where this fungus was collected.
Description. Saprobic on submerged wood in freshwater. Sexual morph: Undetermined. Asexual morph: Hyphomycetous. Colonies sporadic, black, effuse, dense, powdery. Mycelium immersed to superficial, composed of pale brown to brown, septate, branched, smooth-walled hyphae. Conidiophores 2–5 µm wide, macronematous to semi-macronematous, subcylindrical, straight or slightly flexuous, consisting of 1–3 cells, smooth-walled, pale brown to brown, sometimes reduced to conidiogenous cells, arising from lateral and terminal on a hypha. Conidiogenous cells 3–5 × 3–5 µm ( = 4 × 4, n = 20), monoblastic, lateral to terminal, thick-walled, cupulate to subglobose, dark brown, verruculose. Conidia 9–21 × 4–6 µm ( = 16 × 5, n = 40), solitary or in branched chains, acrogenous, phragmosporous, verruculose, straight or slightly curved, rounded at both ends, often paler at apex, thick-walled, composed of subglobose cells, 1–4-septate, constricted at the septa, pale brown to dark brown, monilioid. Conidial secession schizolytic.
Culture characteristics. Colonies on PDA reaching 20 mm in diameter after 8 days at 25 °C. Cultures from above, circular, cream to greenish-white, dense, entire edge, velvety, covered with fluffy-like aerial mycelium, umbonate, slightly radiating in the lower part; reverse orange at the center, light brown, radiating outwardly; reverse greenish gray at the center, white radiating outwardly, without pigment produced in PDA.
Material examined. CHINA, Jilin Province, Changchun city, Jinyue district, Jingyuetan national forest park, on submerged wood, 18 October 2023, Rong Xu, HO1 (HMJAU 64900, holotype), ex-type living culture EMFCC 0042; HO1b (HMJAU 70080, isotype), living culture EMFCC 0046.
Notes. In morphology, our new isolate matched with the generic concept of the genus Torula in having monoblastic, terminal, or lateral conidiogenous cells, and acropetal chains of dark phragmoconidia [3,51,52]. In the multi-gene phylogenetic analysis, Torula changchunensis is closely related to T. chinensis (UESTCC 22.0085) and T. phytolaccae (ZHKUCC 22-0107, ZHKUCC 22-0108). However, it differs from T. chinensis and T. phytolaccae by smaller conidiogenous cells (3–5 × 3–5 µm vs. 5–8 × 5–7 µm vs. 4–6.7 × 5–7.7 μm), smaller conidia (9–21 × 4–6 µm vs. 6–37 × 4–8 µm vs. (9–)20–34 (−63) × 5–9 µm), and fewer septa (1–4 vs. 1–7 vs. 2–12) [11,53].
In a BLASTn search of GenBank, the closest match to the ITS sequence had 98.11% similarity to T. chinensis (UESTCC 22.0085), and the closest match to the LSU sequence had 97.56% similarity to T. herbarum (CBS 246.57), while the tef1-α and rpb2 genes showed 96.23% and 98.68% similarity with T. phytolaccae (ZHKUCC 23-0884) and T. phytolaccae (ZHKUCC 22-0108), respectively. Therefore, we introduced T. changchunensis as a novel species based on the significant differences in morphology and phylogeny.
3.3. Preliminary Assessment of Antagonistic Activity on Pathogens
The growth inhibition and radial growth of B. cinerea and C. mycophilum in the control and test Petri plates are shown in Table 2 and Figure 4. T. changchunensis (EMFCC 0042) demonstrated a stronger resistance to C. mycophilum compared to other strains. Specifically, T. changchunensis (EMFCC 0042) exhibited a potent inhibition effect against C. mycophilum at 67.18 ± 0.0169%, whereas its inhibition against B. cinerea was moderate (19.01 ± 0.0406%). In addition, the moderate inhibitory activity of T. mackenziei (CCMJ 13080) against B. cinerea and C. mycophilum was 10.20 ± 0.0182% and 24.57 ± 0.0259%, respectively (Table 2).

Table 2.
Percentage of growth inhibition (PGI) in in vitro antagonistic activity of Torula species against two pathogenic fungi after 7 days at 25 °C. Data are means of percentage of growth inhibition ± standard deviation (SD). Different letters in the same column indicate statistically significant differences between values. The coefficients *a* and *b* indicate significant differences between the groups.

Figure 4.
In vitro growth inhibition of Torula species (left colonies) against fungal pathogens (right colonies) 7 days after the start of the confrontation. (A) CK: Botrytis cinerea vs. Bo. cinerea. (B) T. changchunensis (EMFCC 0042) vs. Bo. cinerea. (C) T. mackenziei (CCMJ 13080) vs. Bo. cinerea. (D) Control Check (CK): Cladobotryum mycophilum vs. C. mycophilum. (E) T. changchunensis (EMFCC 0042) vs. C. mycophilum. (F) T. mackenziei (CCMJ 13080) vs. C. mycophilum.
The antagonistic activity of T. changchunensis (EMFCC 0042) and T. mackenziei (CCMJ 13080) against two pathogenic bacteria is shown in Figure 5. The antagonistic reactions between T. changchunensis (EMFCC 0042) and S. aureus and B. subtilis were significant (11.79 ± 1.0496a, 13.57 ± 1.6085a). However, T. mackenziei (CCMJ 13080) exhibited barely any inhibition activity against the two tested pathogenic bacteria, and the diameters of the inhibition zones were 6.30 mm and 6.13 mm, respectively.
Figure 5.
The antagonistic activity of Torula species against pathogenic bacteria 24 h after the start of the confrontation. (A) T. mackenziei (CCMJ 13080) vs. S. aureus. (B) T. mackenziei (CCMJ 13080) vs. B. subtilis. (C) T. changchunensis (EMFCC 0042) vs. S. aureus. (D) T. changchunensis (EMFCC 0042) vs. B. subtilis.
4. Discussion
Due to the lack of molecular data for most Torula species, taxonomic confusion persists within this genus; some species may in fact be conspecific or belong to other genera [11]. For example, Torula rhombica and T. terrestris were transferred to the genus Bahusandhika based on morphological characteristics by Crane and Miller [3]. He et al. considered T. longiconidiophora to be a synonym of T. sundara based on phylogenetic analysis, despite differences in conidial size [10]. Therefore, it is necessary to further investigate the taxonomic status of Torula epithets that were established prior to the advent of Sanger sequencing. With the development of molecular biology, relationships among Torula species have become clearer, and several new species have been identified through combined multi-locus phylogenetic analyses and morphological characterization [5,8,11,24,53,54,55,56]. In this study, we report two Torula species from northeastern China based on multi-locus phylogeny combined with morphological features. Phylogenetic analysis revealed that Torula phytolaccae, T. chinensis, and T. changchunensis cluster together in a subclade with 57% ML/1.00 BPP support. Although these species share some morphological similarities, T. changchunensis can be distinguished by its significantly smaller conidiogenous cells, smaller conidia, and fewer septa.
Jilin Province, located in northeastern China, belongs to the temperate climatic zone, which is characterized by harsh winters with minimum temperatures reaching as low as −20 °C [54]. Owing to its unique geographical location and climate, we discovered a novel Torula species on submerged wood in this region, consistent with the genus’s typical ecological preferences. In southern China, Torula species are also commonly found as saprobes in aquatic environments [57]. Our findings contribute to the known species diversity of Torula in China (Table 3) and emphasize the importance of microfungal diversity studies. Additionally, we report a new record of T. mackenziei from the decaying branches of X. sorbifolium (Sapindaceae), an endemic tree in northern China [58]. Previously, T. mackenziei was collected from B. pilosa in Chiang Rai, Thailand, and from submerged wood in Yunnan Province, China. These regions are located in tropical and subtropical zones, respectively, whereas Jilin Province lies in a temperate zone. According to earlier studies, members of Torula have been frequently associated with hosts from the family Asteraceae [8,56]. Our study extends the known host range of T. mackenziei to different environments, suggesting that northeastern China supports a broader diversity of these fungi.

Table 3.
Checklist of Torula species recorded in China.
The genus Torula has been shown to produce a wide array of secondary metabolites [27,28,29,30,31,32]. In this study, the antagonistic activity of two isolates against pathogens was evaluated in vitro. Torula changchunensis (EMFCC 0042) exhibited the strongest inhibitory effect against C. mycophilum, a causative agent of cobweb disease in several important mushroom crops [59,60]. Our results suggest that T. changchunensis holds promise as a biocontrol agent for the prevention and management of cobweb disease, contributing to organic, integrated, and sustainable mushroom cultivation practices. Moreover, since several Torula species have demonstrated antimicrobial properties [30,31], further investigation into the antimicrobial potential of additional Torula species would be valuable. However, in this study, only preliminary in vitro screening of antimicrobial activity was conducted. Future research should focus on compound extraction, the screening of secondary metabolites, and the elucidation of antagonistic mechanisms.
Supplementary Materials
The following are available online at https://www.mdpi.com/article/10.3390/microorganisms13071459/s1: Figure S1: Phylogram of Torula generated from maximum likelihood analysis based on combined ITS, LSU, SSU, tef1-α, and rpb2 sequence data.
Author Contributions
Conceptualization, Y.L.; writing—original draft and formal analysis, R.X. and W.S.; data curation, R.X. and Y.Z.; investigation, R.X., Y.Z. and W.S.; methodology, R.X. and Y.Z.; supervision, Y.L.; writing—review and editing, R.X.; funding acquisition, Y.L. All authors have read and agreed to the published version of the manuscript.
Funding
This study was funded by the Program of Creation and Utilization of Germplasm of Mushroom Crop of “111” Project (no. D17014).
Institutional Review Board Statement
Not applicable.
Informed Consent Statement
Not applicable.
Data Availability Statement
The original contributions presented in this study are included in the article/Supplementary Material. Further inquiries can be directed to the corresponding author.
Conflicts of Interest
The authors declare no conflicts of interest.
References
- Sturm, J. Deutschlands Flora Abt III; Die Pilze Deutschlands: Nuremberg, Germany, 1829. [Google Scholar]
- Manawasinghe, I.S.; Calabon, M.S.; Jones, E.B.G.; Zhang, Y.X.; Liao, C.F.; Xiong, Y.R.; Chaiwan, N.; Kularathnage, N.D.; Liu, N.G.; Tang, S.M.; et al. Mycosphere notes 345–386. Mycosphere 2022, 13, 454–557. [Google Scholar] [CrossRef]
- Crane, J.L.; Miller, A.N. Studies in genera Similar to Torula: Bahusaganda, Bahusandhika, Pseudotorula, and Simmonsiella gen. nov. IMA Fungus 2016, 7, 29–45. [Google Scholar] [CrossRef] [PubMed]
- Hyde, K.D.; Hongsanan, S.; Jeewon, R.; Bhat, D.J.; McKenzie, E.H.C.; Jones, E.B.G.; Phookamsak, R.; Ariyawansa, H.A.; Boonmee, S.; Zhao, Q.; et al. Fungal diversity notes 367–490: Taxonomic and phylogenetic contributions to fungal taxa. Fungal Divers. 2016, 80, 1–270. [Google Scholar] [CrossRef]
- Su, X.J.; Luo, Z.L.; Jeewon, R.; Bhat, D.J.; Bao, D.F.; Li, W.L.; Hao, Y.E.; Su, H.Y.; Hyde, K.D. Morphology and multigene phylogeny reveal new genus and species of Torulaceae from freshwater habitats in northwestern Yunnan, China. Mycol. Prog. 2018, 17, 531–545. [Google Scholar] [CrossRef]
- Crous, P.W.; Carris, L.M.; Giraldo, A.; Groenewald, J.Z.; Hawksworth, D.L.; Hemández-Restrepo, M.; Jaklitsch, W.M.; Lebrun, M.H.; Schumacher, R.K.; Stielow, J.B.; et al. The Genera of Fungi—Fixing the application of the type species of generic names—G2: Allantophomopsis, Latorua, Macrodiplodiopsis, Macrohilum, Milospium, Protostegia, Pyricularia, Robillarda, Rotula, Septoriella, Torula, and Wojnowicia. IMA Fungus 2015, 6, 163–198. [Google Scholar] [CrossRef]
- Su, H.Y.; Hyde, K.D.; Maharachchikumbura, S.S.N.; Ariyawansa, H.A.; Luo, Z.L.; Promputtha, I.; Tian, Q.; Lin, C.G.; Shang, Q.J.; Zhao, Y.C.; et al. The Families Distoseptisporaceae fam. nov., Kirschsteiniotheliaceae, Sporormiaceae and Torulaceae, with new species from freshwater in Yunnan Province, China. Fungal Divers. 2016, 80, 375–409. [Google Scholar] [CrossRef]
- Li, J.F.; Phookamsak, R.; Jeewon, R.; Bhat, D.J.; Mapook, A.; Camporesi, E.; Shang, Q.J.; Chukeatirote, E.; Bahkali, A.H.; Hyde, K.D. Molecular taxonomy and morphological characterization reveal new species and new host records of Torula species (Torulaceae, Pleosporales). Mycol. Prog. 2017, 16, 447–461. [Google Scholar] [CrossRef]
- Hongsanan, S.; Hyde, K.D.; Phookamsak, R.; Wanasinghe, D.N.; McKenzie, E.H.C.; Sarma, V.V.; Boonmee, S.; Lücking, R.; Bhat, D.J.; Liu, N.G.; et al. Refined families of Dothideomycetes: Dothideomycetidae and Pleosporomycetidae. Mycosphere 2020, 11, 1553–2107. [Google Scholar] [CrossRef]
- He, S.; Wei, D.; Bhunjun, C.S.; Jayawardena, R.S.; Thiyagaraja, V.; Zhao, Q.; Fatimah, A.O.; Hyde, K.D. Morphology and multi-gene phylogeny reveal a new species of family Torulaceae from Yunnan Province, China. Diversity 2024, 16, 551. [Google Scholar] [CrossRef]
- Tian, W.; Su, P.; Chen, Y.; Maharachchikumbura, S.S.N. Four new species of Torula (Torulaceae, Pleosporales) from Sichuan, China. J. Fungi 2023, 9, 150. [Google Scholar] [CrossRef]
- Nallathambi, P.; Umamaheswari, C. A new disease of ber (Ziziphus mauritiana Lim) caused by Torula herbarum (Pers) link. J. Mycol. Plant Pathol. 2001, 31, 92. [Google Scholar]
- Grabowski, M. The study of new fungus species causing apple sooty blotch. Folia Hortic. 2007, 19, 89–97. [Google Scholar]
- Li, J.; Bhat, D.J.; Phookamsak, R.; Mapook, A.; Lumyong, S.; Hyde, K. Sporidesmioides thailandica gen. et sp. nov. (Dothideomycetes) from northern Thailand. Mycol. Prog. 2016, 15, 1169–1178. [Google Scholar] [CrossRef]
- Crous, P.W.; Schumacher, R.K.; Wood, A.R.; Groenewald, J.Z. The Genera of Fungi—G5: Arthrinium, Ceratosphaeria, Dimerosporiopsis, Hormodochis, Lecanostictopsis, Lembosina, Neomelanconium, Phragmotrichum, Pseudomelanconium, Rutola, and Trullula. Fungal Syst. Evol. 2020, 5, 77–98. [Google Scholar] [CrossRef]
- Boonmee, S.; Wanasinghe, D.N.; Calabon, M.S.; Huanraluek, N.; Chandrasiri, S.K.U.; Jones, G.E.B.; Rossi, W.; Leonardi, M.; Singh, S.K.; Rana, S.; et al. Fungal diversity notes 1387–1511: Taxonomic and phylogenetic contributions on genera and species of fungal taxa. Fungal Divers. 2021, 111, 1–335. [Google Scholar]
- Persoon, C.H. Neuer versuch einer systematischen eintheilung der schwaümme. Neues Mag. Für Die Bot. Ihrem Ganzen Umfange 1794, 1, 63–128. [Google Scholar]
- Crane, J.L.; Schoknecht, J.D. Revision of Torula species. Rutola, a new name for Torula graminis. Can. J. Bot. 1977, 55, 3013–3019. [Google Scholar]
- Mason, E.W. Annotated account of fungi received at the Imperial Mycological Institute. List 2. Fascicle 3 (special part). In Mycological Papers; Commonwealth: Kew, Surrey, England, 1941; Volume 5, pp. 1–144. [Google Scholar]
- Hughes, S.J. Conidiophores, conidia, and classification. Can. J. Bot. 1953, 31, 577–659. [Google Scholar] [CrossRef]
- Subramanian, C.V. Hypomycetes: An Account of Indian Species Except Cercospora; Council of Agricultural Research: New Delhi, India, 1971; pp. 180–189. [Google Scholar]
- Ellis, M.B. Dematiaceous Hyphomycetes; Commonwealth Mycological Institute: Kew, UK, 1971; p. 608. [Google Scholar]
- Ellis, M.B. More Dematiaceous Hyphomycetes; Commonwealth Mycological Institute: Kew, UK, 1976; p. 507. [Google Scholar]
- Hyde, K.D.; Dong, Y.; Phookamsak, R.; Jeewon, R.; Bhat, D.J.; Jones, E.B.G.; Liu, N.G.; Abeywickrama, P.D.; Mapook, A.; Wei, D.; et al. Fungal diversity notes 1151–1276: Taxonomic and phylogenetic contributions on genera and species of fungal taxa. Fungal Divers. 2020, 100, 5–277. [Google Scholar] [CrossRef]
- Nayak, B.K. Enumeration of phylloplane and endophytic fungi from medicinal plant, Solanum nigrum by two different techniques. Int. J. Chem. Concepts 2018, 4, 1–6. [Google Scholar]
- Karmakar, B.; SenGupta, K.; Kaur, A.; Roy, A.; Bhattacharya, S.G. Fungal bio-aerosol in multiple micro-environments from eastern India: Source, distribution, and health hazards. SN Appl. Sci. 2020, 2, 565. [Google Scholar] [CrossRef]
- Chunyu, W.X.; Zhao, J.Y.; Ding, Z.G.; Wang, Y.X.; Han, X.L.; Li, M.G.; Wen, M.L. A new dichlorinated aromatic lactone from the tin mine tailings-derived fungus Torula sp. YIM DT 10072. Chem. Nat. Compd. 2018, 54, 432–434. [Google Scholar] [CrossRef]
- Kadkol, M.V.; Gopalkrishnan, K.S.; Narasimhachari, N. Isolation and characterization of naphthaquinone pigments from Torula herbarum (Pers.). herbarin and dehydroherbarin. J. Antibiot. 1971, 24, 245–248. [Google Scholar] [CrossRef]
- Narasimhachari, N.; Gopalkrishnan, K.S. Naphthaquinone pigments from Torula herbarum: Structure of O-methylherbarin. J. Antibiot. 1974, 27, 283–287. [Google Scholar] [CrossRef]
- Wang, L.; Dong, J.Y.; Song, H.C.; Shen, K.Z.; Wang, L.M.; Sun, R.; Wang, C.R.; Li, G.H.; Li, L.; Zhang, K.Q. Screening and isolation of antibacterial activities of the fermentative extracts of freshwater fungi from Yunnan Province, China. Ann. Microbiol. 2008, 58, 579–584. [Google Scholar] [CrossRef]
- Osmana, M.E.; El-Beih, A.A.; Khatab, O.-K.H.; Moghannem, S.A.M.; Abdullah, N.H. Production of herbarin and dehydroherbarin by endophytic Chaetosphaeronema sp. (KY321184) isolated from Nepeta septemcrenata and evaluation of their bioactivities. S. Afr. J. Bot. 2018, 117, 174–183. [Google Scholar] [CrossRef]
- Geng, W.L.; Wang, X.Y.; Kurtan, T.; Mandi, A.; Tang, H.; Schulz, B.; Sun, P.; Zhang, W. Herbarone, a rearranged heptaketide derivative from the sea hare associated fungus Torula herbarum. J. Nat. Prod. 2012, 75, 1828–1832. [Google Scholar] [CrossRef]
- Senanayake, I.C.; Rathnayaka, A.R.; Marasinghe, D.S.; Calabon, M.S.; Gentekaki, E.; Lee, H.B.; Hurdeal, V.G.; Pem, D.; Dissanayake, L.S.; Wijesinghe, S.N.; et al. Morphological approaches in studying fungi: Collection, examination, isolation, sporulation and preservation. Mycosphere 2020, 11, 2678–2754. [Google Scholar] [CrossRef]
- Crous, P.W.; Gams, W.; Stalpers, J.A.; Robert, V.; Stegehuis, G. MycoBank: An online initiative to launch mycology into the 21st century. Stud. Mycol. 2004, 50, 19–22. [Google Scholar]
- White, T.J.; Bruns, T.D.; Lee, S.B.; Taylor, J.W. Amplification and direct sequencing of fungal ribosomal RNA genes for phylogenetics. PCR Protoc. Guide Methods Appl. 1990, 18, 315–322. [Google Scholar]
- Vilgalys, R.; Hester, M. Rapid genetic identification and mapping of enzymatically amplified ribosomal DNA from several Cryptococcus species. J. Bacteriol. 1990, 172, 4238–4246. [Google Scholar] [CrossRef] [PubMed]
- Carbone, I.; Kohn, L.M. A method for designing primer sets for speciation studies in filamentous ascomycetes. Mycologia 1999, 91, 553–556. [Google Scholar] [CrossRef]
- Rehner, S.A.; Buckley, E. A Beauveria phylogeny inferred from nuclear ITS and EF1-alpha sequences: Evidence for cryptic diversification and links to Cordyceps teleomorphs. Mycologia 2005, 97, 84–98. [Google Scholar] [PubMed]
- Liu, Y.J.; Whelen, S.; Hall, B.D. Phylogenetic relationships among ascomycetes: Evidence from an RNA polymerase II subunit. Mol. Biol. Evol. 1999, 16, 1799–1808. [Google Scholar] [CrossRef]
- Wang, W.P.; Shen, H.W.; Bao, D.F.; Lu, Y.Z.; Yang, Q.X.; Su, X.J.; Luo, Z.L. Two novel species and three new records of Torulaceae from Yunnan Province, China. MycoKeys 2023, 99, 1–24. [Google Scholar] [CrossRef]
- Hall, T.A. BioEdit: A user-friendly biological sequence alignment editor and analysis program for windows 95/98/NT. Nucleic Acids Symp. Ser. 1999, 41, 95–98. [Google Scholar]
- Katoh, K.; Standley, D.M. MAFFT multiple sequence alignment software version 7: Improvements in performance and usability. Mol. Biol. Evol. 2013, 30, 772–780. [Google Scholar] [CrossRef]
- Larsson, A. AliView: A fast and lightweight alignment viewer and editor for large datasets. Bioinformatics 2014, 30, 3276–3278. [Google Scholar] [CrossRef]
- Vaidya, G.; Lohman, D.J.; Meier, R. SequenceMatrix: Concatenation software for the fast assembly of multi-gene datasets with character set and codon information. Cladistics 2011, 27, 171–180. [Google Scholar] [CrossRef]
- Stamatakis, A. RAxML version 8: A tool for phylogenetic analysis and post-analysis of large phylogenies. Bioinformatics 2014, 30, 1312–1313. [Google Scholar] [CrossRef]
- Nylander, J.A.A. MrModeltest 2.0; Program Distributed by the Author; Uppsala University: Uppsala, Sweden, 2004. [Google Scholar]
- Ronquist, F.; Huelsenbeck, J.P. MrBayes 3: Bayesian phylogenetic inference under mixed models. Bioinformatics 2003, 19, 1572–1574. [Google Scholar] [CrossRef] [PubMed]
- Rambaut, A.; Drummond, A. FigTree: Tree Figure Drawing Tool, Version 1.2.2; Institute of Evolutionary Biology: Barcelona, Spain; University of Edinburgh: Edinburgh, UK, 2008. [Google Scholar]
- Skidmore, A.M.; Dickinson, C.M. Colony interactions and hyphal interference between Sepatoria nodorum and Phylloplane Fungi. Trans. Br. Mycol. Soc. 1976, 66, 57–64. [Google Scholar] [CrossRef]
- Hamzah, T.N.T.; Lee, S.Y.; Hidayat, A.; Terhem, R.; Faridah-Hanum, I.; Mohamed, R. Diversity and characterization of endophytic fungi isolated from the tropical mangrove species, Rhizophora mucronata, and identification of potential antagonists against the soil-borne fungus, Fusarium solani. Front. Microbiol. 2018, 9, 1707. [Google Scholar] [CrossRef] [PubMed]
- Scott, J.A.; Untereiner, W.A.; Ewaze, J.O.; Wong, B.; Doyle, D. Baudoinia, a new genus to accommodate Torula compniacensis. Mycologia 2007, 99, 592–601. [Google Scholar] [CrossRef]
- Crous, P.W.; Wingfield, M.J.; Burgess, T.I.; Hardy, G.E.; Crane, C.; Barrett, S.; Cano-Lira, J.F.; Roux, J.J.L.; Thangavel, R.; Guarro, J.; et al. Fungal planet description sheets: 469–557. Persoonia 2016, 37, 218–403. [Google Scholar] [CrossRef]
- Li, Y.X.; Doilom, M.; Dong, W.; Liao, C.F.; Manawasinghe, I.S.; Xua, B. Taxonomic and phylogenetic contribution to Torula: T. phytolaccae sp. nov. on Phytolacca acinosa from China. Phytotaxa 2023, 584, 1–17. [Google Scholar] [CrossRef]
- Luan, S.; Shen, H.W.; Bao, D.F.; Luo, Z.L.; Xia, Y. Morphology and multi-gene phylogeny reveal a novel Torula (Pleosporales, Torulaceae) species from the plateau lakes in Yunnan, China. Biodivers. Data J. 2023, 11, e109477. [Google Scholar] [CrossRef]
- Li, X.H.; Phookamsak, R.; Sun, F.Q.; Jiang, H.B.; Xu, J.C.; Li, J.F. Torula aquilariae sp. nov. (Torulaceae, Pleosporales), a new species associated with Aquilaria sinensis from Yunnan, China. Stud. Fungi 2024, 9, e020. [Google Scholar] [CrossRef]
- Li, J.; Jeewon, R.; Mortimer, P.E.; Doilom, M.; Phookamsak, R.; Promputtha, I. Multigene phylogeny and taxonomy of Dendryphion hydei and Torula hydei spp. nov. from herbaceous litter in northern Thailand. PLoS ONE 2020, 15, e0228067. [Google Scholar] [CrossRef]
- Zhao, Z.; Liang, C.J.; Zhang, W.; Yang, Y.Y.; Bi, Q.X.; Yu, H.Y.; Wang, L.B. Genome-wide association analysis identifies a candidate gene controlling seed size and yield in Xanthoceras sorbifolium Bunge. Hortic. Res. 2024, 11, 243. [Google Scholar] [CrossRef]
- Zheng, P. China’s Geography; China Intercontinental Press: Beijing, China, 2006. [Google Scholar]
- Liu, Z.H.; Cong, Y.L.; Sossah, F.L.; Lu, Y.Z.; Kang, J.C.; Li, Y. Characterization and genome analysis of Cladobotryum mycophilum, the causal agent of cobweb disease of Morchella sextelata in China. J. Fungi 2023, 9, 411. [Google Scholar] [CrossRef]
- Xu, R.; Liu, Z.H.; Fu, Y.P.; Li, Y. Identification and biological characteristics of Cladobotryum mycophilum causing cobweb disease on Ganoderma lingzhi. Mycosystema 2019, 38, 669–678. [Google Scholar]
Disclaimer/Publisher’s Note: The statements, opinions and data contained in all publications are solely those of the individual author(s) and contributor(s) and not of MDPI and/or the editor(s). MDPI and/or the editor(s) disclaim responsibility for any injury to people or property resulting from any ideas, methods, instructions or products referred to in the content. |
© 2025 by the authors. Licensee MDPI, Basel, Switzerland. This article is an open access article distributed under the terms and conditions of the Creative Commons Attribution (CC BY) license (https://creativecommons.org/licenses/by/4.0/).